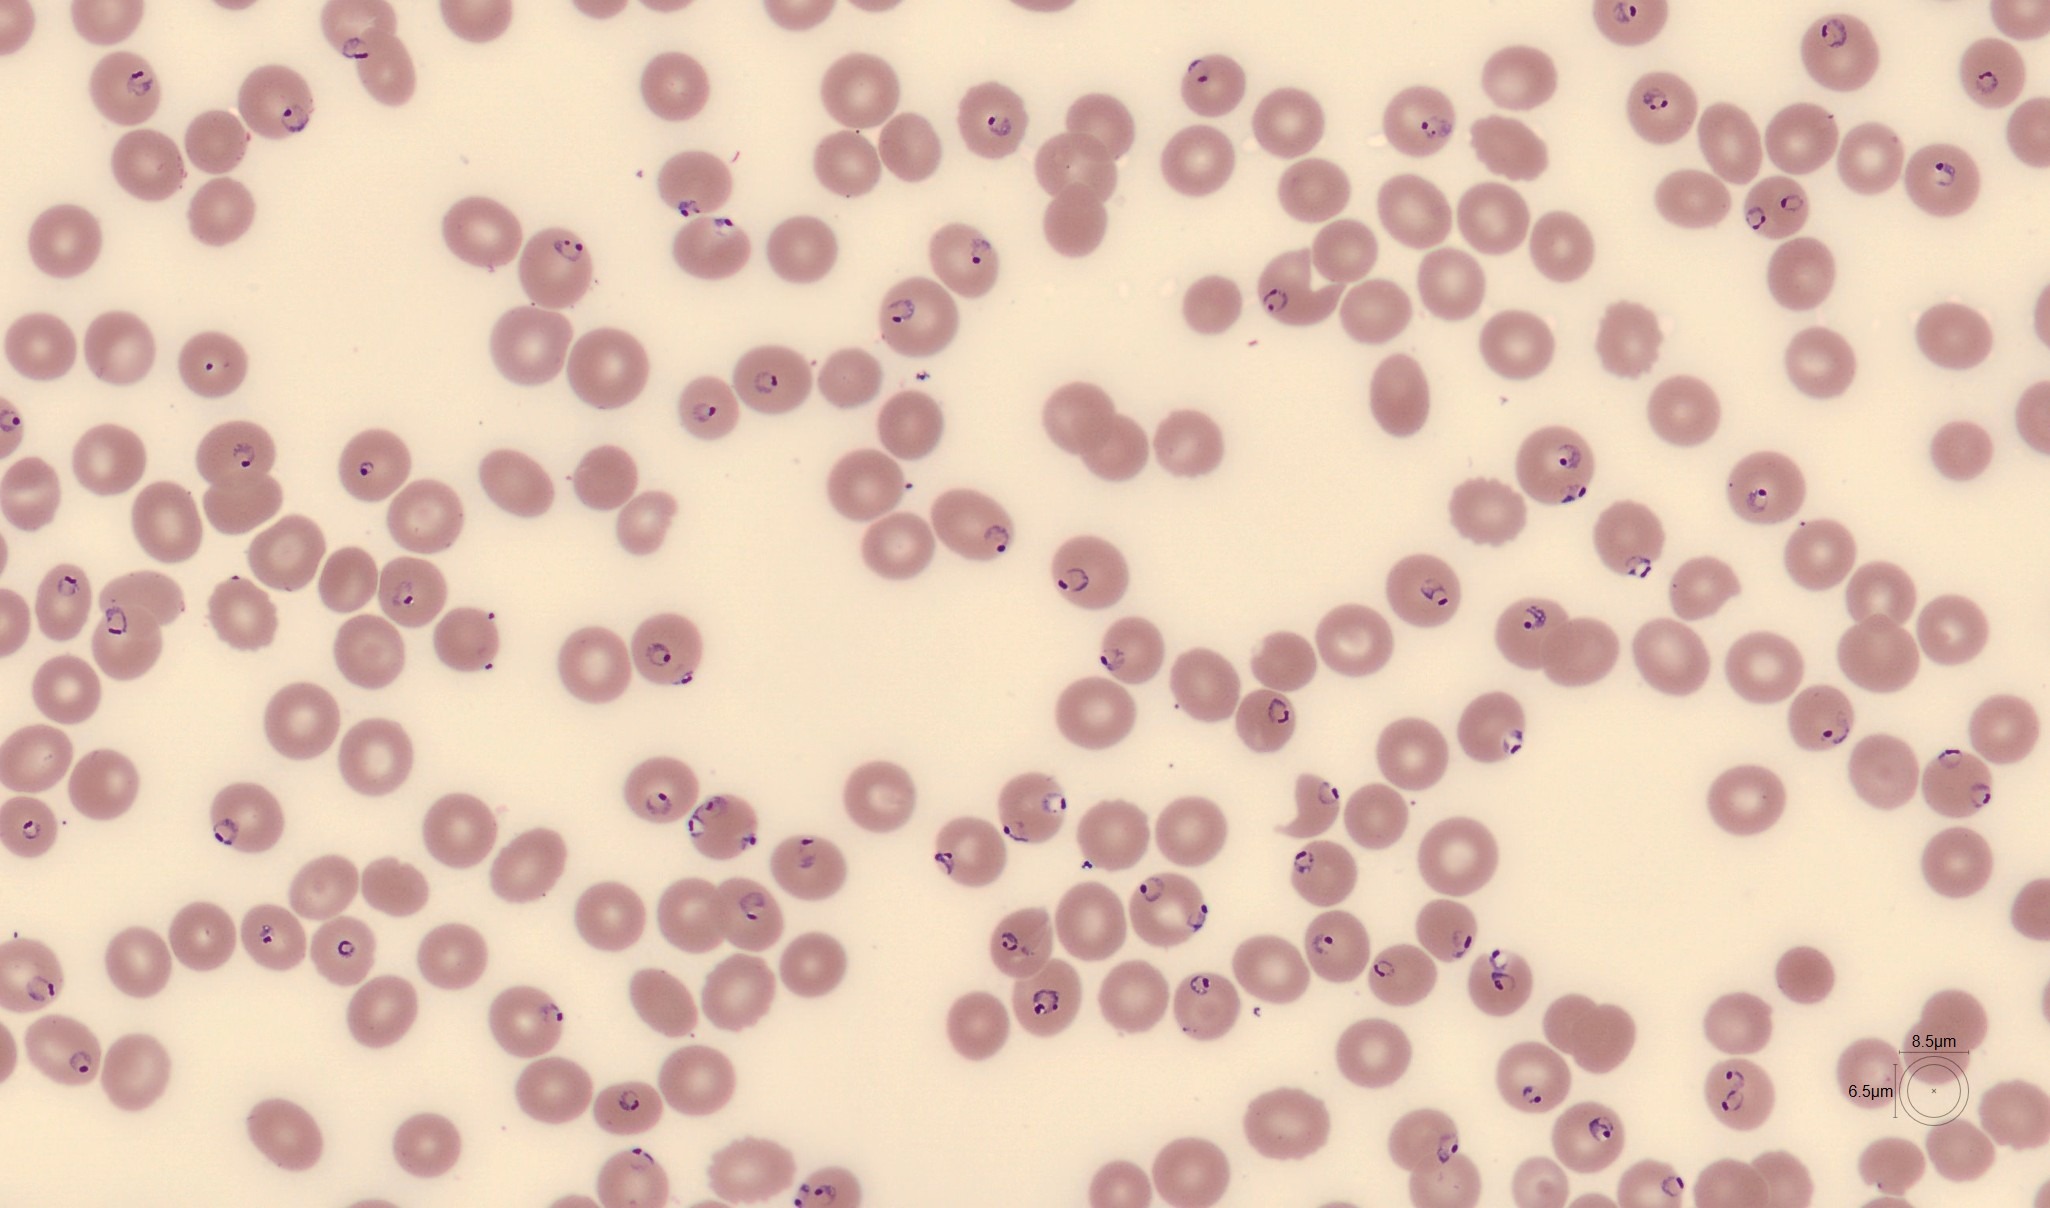
RBC Monthly Cell Challenge February 2026

Monthly Cell Challenge #02 / 2026

The Missing History
A 28-year-old woman presented to the emergency department with a one-week history of intermittent fever and increasing fatigue. She described headache, reduced concentration, and a general feeling of being unwell. The symptoms had fluctuated in intensity and were partially relieved by paracetamol (acetaminophen). She denied cough, sore throat, gastrointestinal symptoms, urinary complaints, or localized pain.
On physical examination, she appeared tired but alert and oriented. Vital signs were stable except for a temperature of 38.2 °C. No lymphadenopathy was noted. Abdominal examination was inconclusive, with no clear hepatosplenomegaly.
Initial clinical assessment suggested a non-specific febrile illness, and routine laboratory investigations were requested.
CBC results:
| Test | Result | Units |
|---|---|---|
| WBC | 3.6 | x109/L |
| HGB | 116 | g/L |
| MCV | 83 | fL |
| PLT | 109 | x109/L |
Blood smear analysis pre-classification on CellaVision DC-1
| WBC Differential | % | x109/L |
|---|---|---|
| Band | 13.8 | 0.5 |
| Neutrophils | 44 | 1.6 |
| Lymphocytes | 33.6 | 1.2 |
| Monocytes | 6.9 | 0.2 |
| Metamyelocytes | 0.9 | 0.0 |
| Plasma cell | 0.9 | 0.0 |
Blood smear findings:




The white blood cell morphology was largely unremarkable with a slight left-shift. However, changes involving the red blood cells were noted in the background of the white blood cell images, which prompted a more detailed review of the red blood cell overview.
In the RBC overview the erythrocytes appear normocytic and normochromic. No significant anisocytosis, poikilocytosis, or polychromasia is observed.
A notable finding is the presence of numerous erythrocytes containing small, delicate intracellular ring-like structures. They are observed both as single ring forms and as multiple ring-like inclusions within the same red blood cell.
Following review of the peripheral blood smear, further history was obtained. The patient had returned two weeks earlier from a vacation in Cape Verde, where she had traveled in both urban areas and along the coast. She did not report any acute illness during the trip and had initially not mentioned the travel history, as she did not consider it relevant at the time of examination.
Diagnosis:
Plasmodium falciparum malaria.
Discussion:
Plasmodium falciparum is the most clinically significant malaria parasite in humans and is responsible for the majority of severe and life-threatening malaria cases worldwide. The parasite infects erythrocytes at all stages of maturation, which explains why red blood cells often remain normocytic and normochromic despite a high parasitemia, particularly in early disease [1,2].
Morphologically, P. falciparum is characterized in peripheral blood smears by small, delicate ring forms, frequently occurring as multiple parasites within a single erythrocyte. Ring forms are often thin and subtle, sometimes with only a faint chromatin dot, and may be located at the periphery of the red blood cell, producing so-called accolé (appliqué) forms. More mature parasite stages are usually not visible in peripheral blood because infected red blood cells adhere to small blood vessels. As a result, diagnosis relies heavily on careful examination of red blood cell morphology [1,2].
This case illustrates how P. falciparum malaria may present with non-specific clinical symptoms and only mild abnormalities in the complete blood count, potentially mimicking viral or inflammatory conditions. As a result, the diagnosis may be delayed unless red blood cell morphology is systematically reviewed. CellaVision digital morphology makes it easier to detect subtle intracellular inclusions by allowing efficient review of many red blood cells and closer evaluation of abnormal red blood cell features.
Malaria transmission in Cape Verde is low, but infection with Plasmodium falciparum can still occur. Patients may not mention recent travel unless specifically asked, making travel history an important part of the assessment in cases of unexplained fever and abnormal blood smear findings. Clear and timely communication between the laboratory and the treating clinician is essential, as delayed recognition may lead to rapid clinical deterioration [2].
According to WHO guidelines, P. falciparum malaria requires prompt treatment. Uncomplicated cases are treated with artemisinin-based combination therapy (ACT), while severe cases or patients unable to take oral medication should receive intravenous artesunate followed by oral ACT once clinically stable. Early diagnosis and timely treatment are essential to prevent complications and reduce mortality [3].
References:
[1] Bain BJ. Blood cells: a practical guide. 6th ed. Oxford: Wiley-Blackwell; 2020.
[2] World Health Organization. WHO guidelines for malaria. Geneva: World Health Organization; 2023. Available from: https://www.who.int/publications/i/item/guidelines-for-malaria
[3]Centers for Disease Control and Prevention. DPDx – laboratory identification of malaria parasites [Internet]. Atlanta (GA): CDC; [accessed 2026 Jan]. Available from: https://www.cdc.gov/dpdx/malaria